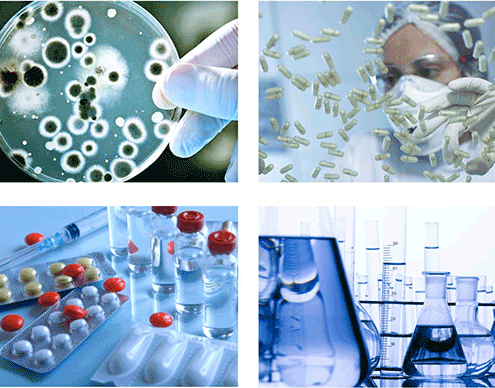

http://ozonespidar.com/wp-content/uploads/2019/01/DMimpresa_ES-ozone.jpg
426
500
ozonespidar
http://ozonespidar.com/wp-content/uploads/2021/08/ozonespidar_logo-1-266x300.png
ozonespidar2019-01-16 11:55:582019-09-14 19:41:22تاییدهای سازمانی جهانی ازن
http://ozonespidar.com/wp-content/uploads/2019/01/DMimpresa_ES-ozone.jpg
426
500
ozonespidar
http://ozonespidar.com/wp-content/uploads/2021/08/ozonespidar_logo-1-266x300.png
ozonespidar2019-01-16 11:55:582019-09-14 19:41:22تاییدهای سازمانی جهانی ازناخرین اخبار
هرچیزی که درباره شرکت ماست
اصلاً اهمیتی ندارد که از این قالب چه استفاده ای خواهید کرد،
در هر صورت شما بهترین ظاهر و بیشترین کارایی را خواهید داشت.
 http://ozonespidar.com/wp-content/uploads/2019/01/DMimpresa_ES-ozone.jpg
426
500
ozonespidar
http://ozonespidar.com/wp-content/uploads/2021/08/ozonespidar_logo-1-266x300.png
ozonespidar2019-01-16 11:55:582019-09-14 19:41:22تاییدهای سازمانی جهانی ازن
http://ozonespidar.com/wp-content/uploads/2019/01/DMimpresa_ES-ozone.jpg
426
500
ozonespidar
http://ozonespidar.com/wp-content/uploads/2021/08/ozonespidar_logo-1-266x300.png
ozonespidar2019-01-16 11:55:582019-09-14 19:41:22تاییدهای سازمانی جهانی ازن http://ozonespidar.com/wp-content/uploads/2019/01/ozone-gene.png
361
542
ozonespidar
http://ozonespidar.com/wp-content/uploads/2021/08/ozonespidar_logo-1-266x300.png
ozonespidar2019-01-16 11:05:082019-09-14 18:29:53خصوصیات ذاتی وعمومی ازن
http://ozonespidar.com/wp-content/uploads/2019/01/ozone-gene.png
361
542
ozonespidar
http://ozonespidar.com/wp-content/uploads/2021/08/ozonespidar_logo-1-266x300.png
ozonespidar2019-01-16 11:05:082019-09-14 18:29:53خصوصیات ذاتی وعمومی ازن
ارگانیسمهای که ازن ازبین میبرد
مکانیسم عمل ازن بر روی باکتریها ویروس ها وقارچها
باکتریها میکروار…
 http://ozonespidar.com/wp-content/uploads/2019/01/cfc_anm2.gif
300
400
ozonespidar
http://ozonespidar.com/wp-content/uploads/2021/08/ozonespidar_logo-1-266x300.png
ozonespidar2019-01-14 15:38:212019-09-17 21:07:50ازن چیست?
http://ozonespidar.com/wp-content/uploads/2019/01/cfc_anm2.gif
300
400
ozonespidar
http://ozonespidar.com/wp-content/uploads/2021/08/ozonespidar_logo-1-266x300.png
ozonespidar2019-01-14 15:38:212019-09-17 21:07:50ازن چیست?
پیدایش اولیه ازن
ازن در سال 1785توسط فیزیکدان هلندی مارتینوس ون ماروم (1837-1750)کشف شد که از…
 اخذ وارائه مشاوره درصنعت کشاورزی وصنایع غذاییجولای 15, 2015 - 3:48 ب.ظ
اخذ وارائه مشاوره درصنعت کشاورزی وصنایع غذاییجولای 15, 2015 - 3:48 ب.ظ اخذ وارائه مشاوره درصنعت پزشکیجولای 15, 2015 - 3:48 ب.ظ
اخذ وارائه مشاوره درصنعت پزشکیجولای 15, 2015 - 3:48 ب.ظ فعالیت شرکت درداخل وخارج ازکشورجولای 15, 2015 - 3:46 ب.ظ
فعالیت شرکت درداخل وخارج ازکشورجولای 15, 2015 - 3:46 ب.ظ مدارکات وتاییده های بین المللی ازنجولای 15, 2015 - 3:41 ب.ظ
مدارکات وتاییده های بین المللی ازنجولای 15, 2015 - 3:41 ب.ظ
دستهها
عضویت درمقالات علمی

کجا ما را پیدا کنید
آدرس :تهران - اتوبان امام علی جنوبی - پایین تر از پیروزی - جنب پارک امام علی - پلاک 23
تلفن واحدفروش: 09331844848
تلفن واحدپشتیبانی: 09331844848
شبکه های اجتماعی شرکت
ایمیل شرکت: info@ozonespidar.com sales@ozonespidar.com
شبکه های احتماعی: ozonespidar@
ساعت کاری شرکت
بخش فروش: هر روز از ساعات 8 الی 17 - به جز روزهای تعطیل .
بخش پشتیبانی فنی : 24ساعته میباشد(حتی درروزهای تعطیل ) .
